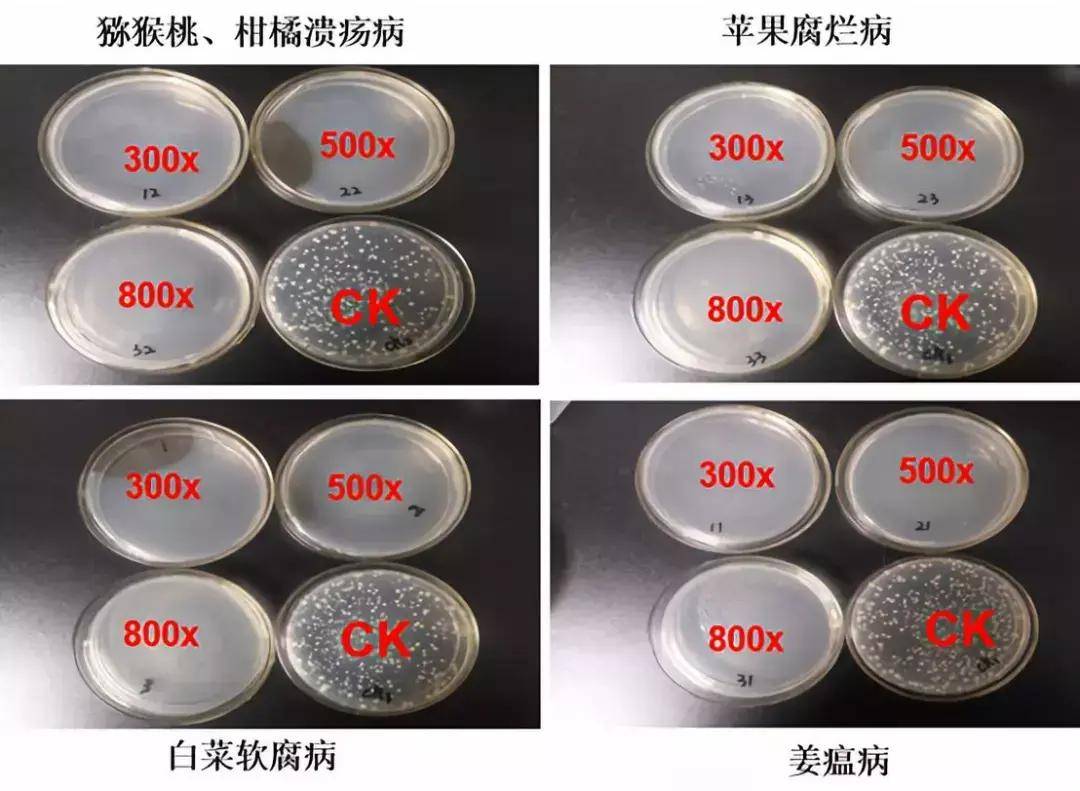
生物农药:ce大蒜素—源自大蒜 防细菌性病害!_防治_制剂_作用

ce角正常值

读书笔记发育性髋关节发育不良临床诊疗指南2016
图片尺寸640x477
测量髋关节ce角在髋关节疾病临床中的应用
图片尺寸1470x2070
切开复位骨盆salter截骨术治疗发育性髋关节脱位的长期随访研究
图片尺寸366x300
髋臼角和ce角doc
图片尺寸792x1120
临床状况-ce
图片尺寸374x268
角鮟鱇亚目( ceratioidei),是鮟鱇目( lophiiformes)下一个极为特化的
图片尺寸2189x14226,六期,x线表现脱位,ce角为负值,假关节形成,反复脱位.
图片尺寸1080x871
ce角:也称中心边缘角(如上图):指双侧股骨头中心点的连线的垂线与与
图片尺寸640x378
评估内容:股骨头的前方覆盖程度,前方前倾角,与ce角类似,正常时> 25
图片尺寸660x342
我的发育性髋关节发育不良ce角是多少?
图片尺寸510x481
生物农药:ce大蒜素—源自大蒜 防细菌性病害!_防治_制剂_作用
图片尺寸509x467
生物农药:ce大蒜素—源自大蒜 防细菌性病害!_防治_制剂_作用
图片尺寸1080x531
4 第1课时 圆心角定理
图片尺寸560x6243ce新品眼影套装02糙汉型试色
图片尺寸1080x1080
cf,则ef‖bd,∴异面直线ce与bd所成的角即为ce与ef所成的角∠cef
图片尺寸652x787
1第1课时平行四边形的边角的特征学案(新版)新人教版
图片尺寸682x588
生物农药:ce大蒜素—源自大蒜 防细菌性病害!_防治_制剂_作用
图片尺寸766x162
生物农药:ce大蒜素—源自大蒜 防细菌性病害!_防治_制剂_作用
图片尺寸1080x791
如图ce是三角形abc的外角
图片尺寸472x304
a new radiographic incidence for the study of the hip.
图片尺寸800x1086
猜你喜欢:髋臼指数正常值ce角ce角测量示意图血常规正常值图片血糖正常值心率正常值甲胎蛋白正常值hcg正常值对照表d二聚体正常值范围孕酮正常值是多少空腹血糖正常值血糖正常值对照表尿酸正常值范围指尖血糖正常值对照表心电图正常值范围hcg正常值对照表图片心率正常值范围是多少60岁血糖正常值怀孕hcg正常值对照表最新血糖正常值对照表听力测试正常值早孕三项正常值图血糖正常值表格图片血糖正常值糖尿病声导抗测试正常值图片性激素六项正常值图片纯音测听正常值图Q角第一代恒星女王s旖旎多乐士脏粉色王者荣耀打野头像职业撑杆跳女运动员死亡电动筛沙机月亮上的女孩真人奇形怪状的打火机快手何芳芳青海青 黄河黄火之魔王兽画画西柏坡剪纸